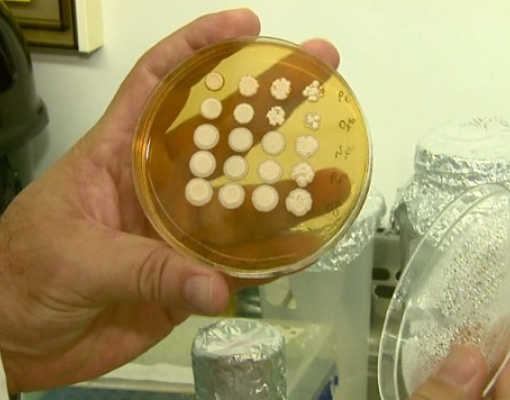

Pesquisa da UFSCar identifica fungos para aumentar a produção de etanol
10-04-2017
Uma pesquisa desenvolvida por estudantes e professores da Universidade Federal de São Carlos (UFSCar) avalia alternativas para aumentar a produção de etanol. Foram identificados alguns fungos usados na fabricação que podem tornar o processo mais eficiente. Com mais oferta no mercado, a tendência é que os preços caiam.
Os pesquisadores do curso de biotecnologia descobriram uma forma de melhorar a fabricação do combustível a partir da seleção de um fungo, usado na transformação do açúcar do caldo de cana em combustível. Geralmente vão para o tanque vários tipos desses fungos, chamados de leveduras. Nessa mistura tem as boas, mas também as ruins no processo de fermentação, porque interferem na capacidade de produção.
O problema pode ser resolvido quando é isolada uma levedura ideal para o ambiente da usina. "Leveduras que se desenvolvem bem em uma determinada usina, muitas vezes não se desenvolvem com a mesma capacidade numa usina, às vezes vizinha", disse o pesquisador da UFSCar Anderson Ferreira da Cunha.
Segundo os pesquisadores, a padronização do processo pode levar a uma redução de custos. Durante a pesquisa, foram coletadas amostras de várias usinas do Estado de São Paulo. Na usina São Luís, em Ourinhos, eles conseguiram identificar uma levedura que pode aumentar a produção em até 20%, isso porque ela levou menos tempo para transformar o açúcar em etanol.
Andamento
O estudo teve início em 2009 e até o momento os pesquisadores já identificaram quatro tipos de leveduras capazes de suportar temperaturas mais altas, acima dos 40 graus.
Como os tanques de fermentação trabalham entre 30 e 33 graus, isso permite reduzir os custos porque serão usados menos equipamentos para resfriar e com temperaturas mais elevadas, as leveduras consideradas ruins não conseguem sobreviver.
Outra vantagem apontada pela pesquisa é que o tempo de produção deve ser otimizado, de oito horas para seis. "Uma vez que você vai ter menos oscilações do processo, vai ter provavelmente leveduras que transformem a mesma quantidade de açúcar na mesma quantidade de etanol, mas num tempo menor do que as atualmente empregadas, com isso você ganharia tempo de processo e uma vez tendo caldo de cana para fermentar, você poderia produzir um volume maior de etanol no mesmo tempo”, disse o professor e pesquisador.
Até o momento, os experimentos foram feitos apenas em laboratório. Os testes na usina devem começar no início de 2018.





